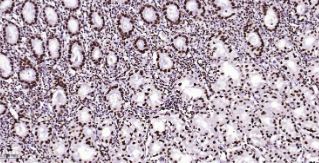

Human Histone H4 Ready-To-Use IHC Kit
Human Histone H4 Ready-To-Use IHC Kit
Cat. No.: IHC0484HSample Type: FFPE tissue
Size: 50T (including a control slide)
Storage and Stability: Please store components at the temperatures indicated on the individual tube labels. The kit is stable for 6 months from the date of receipt.
Background
Histones are basic nuclear proteins that are responsible for the nucleosome structure of the chromosomal fiber in eukaryotes. Two molecules of each of the four core histones (H2A, H2B, H3, and H4) form an octamer, around which approximately 146 bp of DNA is wrapped in repeating units, called nucleosomes. The linker histone, H1, interacts with linker DNA between nucleosomes and functions in the compaction of chromatin into higher order structures. This gene is intronless and encodes a member of the histone H4 family. Transcripts from this gene lack polyA tails but instead contain a palindromictermination element. This gene is found in the large histone gene cluster on chromosome 6.
Synonyms
dJ160A22.2; FO108; H4; H4-12; H4-16; H4-53; H4/A; H4/B; H4/C; H4/D; H4/E; H4/G; H4/H; H4/I; H4/J; H4/K; H4/M; H4/N; H4/O; H4/p; H4C1; H4C11; H4C12; H4C13; H4C14; H4C15; H4C16;H4C2; H4C3; H4C4; H4C5; H4C6; H4C8; H4C9; H4f16; H4F2; H4F2iv; H4FA; H4FB; H4FC; H4FD; H4FE; H4FG; H4FH; H4FI; H4FJ; H4FK; H4FM; H4FN; H4FO; H4M; HIST1H4A; HIST1H4B; HIST1H4C; HIST1H4D; HIST1H4E; HIST1H4F; HIST1H4H; HIST1H4I; HIST1H4J; HIST1H4K; HIST1H4L; Hist1h4m; HIST2H4; HIST2H4A; HIST2H4B; HIST4H4; X04652; HIST1H4; HISTH4H4; methyl histone H4;histone H4; H4_HUMAN; Osteogenic growth peptide; OGP.Validation Data
Materials Supplied
| Number | Component | 50T | Concentration | Storage |
|---|---|---|---|---|
| 1 | PBS Buffer (powder) | 2L x 2 | 20x | RT |
| 2 | Antigen Retrieval Buffer | 20ml | 100x | 2-8°C |
| 3 | Endogenous Peroxidase Blocking Buffer | 3ml | RTU | 2-8°C |
| 4 | Blocking Buffer | 3ml | RTU | 2-8°C |
| 5 | "Primary Antibody (Human Histone H4 Recombinant Rabbit mAb) | "6ml | RTU | 2-8°C |
| 6 | "Secondary Antibody (Goat Anti-Rabbit IgG H&L, HRP conjugated) | "6ml | RTU | 2-8°C |
| 7 | Chromogen Component A | 0.3ml | RTU | -20°C |
| 8 | Chromogen Component B | 0.3ml | RTU | -20°C |
| 9 | Counter Staining Reagent | 5ml | RTU | RT |
| 10 | Differentiation Reagent | 6ml | RTU | RT |
| 11 | Mounting Media | 5ml | RTU | RT |
| 12 | Control slide (human brain) | 1 slide | RTU | RT |
| 13 | Datasheet | 1 copy |
Notes
- The positive control slide provided in the kit allows you to be sure that the experimental set-up is working properly.
- Do not allow slides to dry at any time during this procedure.
- Please don't replace the matching reagents in this product with other manufacturers' products.
- As DAB is a carcinogen, please take necessary precautions.
- PBS (reagent 1) can be stored for one week at 4℃ after preparation; The antigen retrieval buffer (1×reagent 2) and the chromogenic agent (the mixture of reagents 7 and 8) should be prepared right before each assay.
As DAB is a carcinogen, please take necessary precautions.
Important Note: This product as supplied is intended for research use only, not for use in human, therapeutic or diagnostic applications.